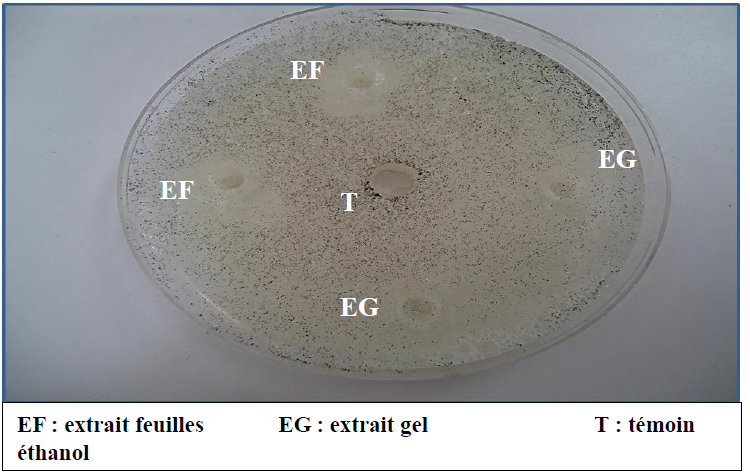

a. Activité anti-radicalaire
Le 2,2-diphényl-1-picrylhydrazyl (DPPH) est un radical libre largement utilisé pour évaluer l’activité antioxydante. La méthode est basée sur la capacité des composés à agir en tant que piégeurs de ce radical en donnant un atome d’hydrogène. La caractéristique principale d’un antioxydant est sa capacité de capter les radicaux libres.
L’activité anti-radicalaire exprimée par le % d’inhibition du radical DPPH des extraits éthanoliques du gel et de la feuille d’Aloe arborescence est représentée dans la figure 19 et la corrélation entre cette activité et les teneurs en polyphénols totaux et flavonoïdes en figure 20.
Figure 19 : Pourcentage d’inhibition du radical DPPH des extraits éthanoliques du gel et feuilles d’Aloe arborescens
Figure 20 : Corrélation entre le % d’inhibition du radical DPPH et la teneur en polyphénols et en flavonoïdes des extraits du gel et de la feuille d’Aloe arborescens
Les résultats de pourcentage d’inhibition du radical DPPH des extraits éthanoliques du gel et feuilles sont significativement déférents (test student) (P < 0,05).
Le pourcentage d’inhibition du radical DPPH des extraits éthanoliques étudiés varie entre 14,05 ± 0,16 (gel) à 41,66 ± 2,89 % (feuilles) de 5mg/mL et 4mg /mL respectivement.
Selon la figure 20, on remarque une corrélation entre la teneur en phénols totaux, flavonoïdes et le pourcentage d’inhibition du radical DPPH. Donc l’activité anti-radicalaire est proportionnelle à la quantité en polyphénols et flavonoïdes.
Nos résultats sont supérieurs à ceux rapportés par Lee et ses collaborateurs (2012), dont l’extrait de la feuille a un pourcentage d’inhibition de 35 ± 2,02 %, avec un pourcentage de 12,3 ± 0,12 % pour le gel. Cette différence est probablement due à la différence du solvant, la méthode d’extraction et de dosage.
b. Activité antibactérienne
Cette partie du travail, vise à montrer la présence d’une activité antibactérienne des deux extraits de gel et feuilles sur les souches bactériennes : Escherichia coli et Staphylococcus aureus. Le choix de ces bactéries s’est porté sur des souches fréquentes en pathologie humaine, appartenant à deux catégories différentes. Ces deux espèces bactériennes sont responsables souvent d’infections nosocomiales, qui constituent un problème majeur de santé publique. L’émergencede la multi-résistance chez ces bactéries est une des principales causes d’échec thérapeutique l’efficacité des produits testés ainsi que leur modalité de pénétration dans la bactérie sont différentes (Kaloustian et al., 2008).
Pour évaluer cette activité, nous avons opté pour la méthode des disques, une méthode de diffusion sur gélose. Les valeurs exprimant les diamètres des zones d’inhibition sont présentées dans le tableau 15.
Tableau 13 : Zone d’inhibition (mm) des extraits de la feuille et du gel d’Aloe arborescens sur Escherichia coli et Staphylococcus aureus
(-) : absence de zone d’inhibition
Escherichia coli montre une sensibilité vis-à-vis de l’extrait éthanolique de la feuille (1,25mg/mL) supérieure à celle de l’extrait gel (2 mg/ mL). Celle-ci se traduit par l’apparition des zones d’inhibition importantes qui entourent les disques imprégnés par l’extrait de la feuille (22 ± 0,24 mm) que du gel (16 ±1,63 mm). L’éthanol ne montre aucune activité antibactérienne en raison de l’absence complète d’une zone d’inhibition au tour des disques témoins.
Staphylococcus aureus résiste aux deux extraits étudiés, suite à l’absence totale de zone d’inhibition.
Ces résultats sont en accord avec ceux de Moody et ses collaborateurs (2004). La teneur en polyphénols et leurs modalités de pénétration dans la bactérie sont les paramètres qui déterminent le taux d’inhibition (Habeeb et al., 2007).
c. Activité antifongique
Les propriétés antifongiques d’Aloe arborescens ont été vérifiées sur le champignon Trichoderma viride. Pour mieux évaluer cette activité nous avons opté pour la méthode des puits, une méthode de diffusion sur gélose. Les valeurs exprimant les diamètres des zones d’inhibition sont présentées dans le tableau 14 et figure 21. L’éthanol ne montre aucune activité antifongique.
Tableau 14 : Zone d’inhibition (mm) des extraits de la feuille et du gel d’Aloe arborescens sur Trichoderma viride
Figure 21 : Activité antifongique du gel et des feuilles d’Aloe arborescens vis-à-vis de Trichoderma viride
L’espèce Trichoderma viride présente des réactions variables en présence de l’extrait des feuilles d’Aloe arborescens est du gel ; elle est plus sensible vis-vis de l’extrais de la feuille que du gel.
Cette sensibilité se traduit par l’apparition des zones d’inhibition importante qui entourent les disques (17,3 ± 0,12 mm pour la feuille et 16 ± 0,081 mm pour le gel).
Nos résultats sont proches à ceux de Jasso et al., (2005), où l’extrait de la feuille a une zone d’inhibition de 15,2 ± 0,01 mm de diamètre.